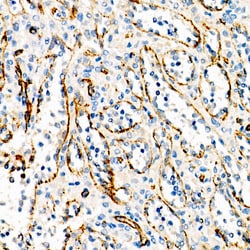
Invitrogen VE-cadherin Recombinant Rabbit Monoclonal Antibody (9W5E3):Antibodies:Primary

Learn More
Invitrogen™ VE-cadherin Recombinant Rabbit Monoclonal Antibody (9W5E3)
Description
Immunogen sequence: DWIWNQMHID EEKNTSLPHH VGKIKSSVSR KNAKYLLKGE YVGKVFRVDA ETGDVFAIER LDRENISEYH LTAVIVDKDT GENLETPSSF TIKVHDVNDN WPVFTHRLFN ASVPESSAVG TSVISVTAVD ADDPTVGDHA SVMYQILKGK EYFAIDNSGR IITITKSLDR EKQARYEIVV EARDAQGLRG DSGTATVLVT LQDINDNFPF FTQTKYTFVV PEDTRVGTSV GSLFVEDPDE PQNRMTKYSI LRGDYQDAFT IETNPAHNEG IIKPMKPLDY EYIQQYSFIV EATDPTIDLR YMSPPAGNRA QVIINITDVD EPPIFQQPFY HFQLKENQKK PLIGTVLAMD PDAARHSIGY SIRRTSDKGQ FFRVTKKGDI YNEKELDREV YPWYNLTVEA KELDSTGTPT GKESIVQVHI EVLDENDNAP EFAKPYQPKV CENAVHGQLV LQISAIDKDI TPRNVKFKFI LNTENNFTLT DNHDNTANIT VKYGQFDREH TKVHFLPVVI SDNGMPSRTG TSTLTVAVCK CNEQGEFTFC EDMAAQ.

Specifications
Specifications
| Antigen | VE-cadherin |
| Applications | ELISA, Immunohistochemistry (Paraffin), Western Blot |
| Classification | Recombinant Monoclonal |
| Clone | 9W5E3 |
| Concentration | 0.13 mg/mL |
| Conjugate | Unconjugated |
| Formulation | PBS with 0.05% BSA, 50% glycerol and 0.05% ProClin 300; pH 7.3 |
| Gene | CDH5 |
| Gene Accession No. | P33151 |
| Gene Alias | 7B4; 7B4 antigen; 7B4/cadherin-5; AA408225; cadherin 5; cadherin 5, type 2 (vascular endothelium); cadherin 5, type 2, VE-cadherin (vascular endothelium); cadherin 5, type 2, VE-cadherin (vascular epithelium); cadherin-5; cadherin-5; cd144 antigen; VE cadherin; Cd144; cd144 antigen; CDH5; cell-cell adhesion protein; endothelial-specific cadherin; vascular endothelial cadherin; vascular endothelial cadherin precursor; Vec; VEcad; VE-Cad; VE-cadherin; VECD |
| Show More |
By clicking Submit, you acknowledge that you may be contacted by Fisher Scientific in regards to the feedback you have provided in this form. We will not share your information for any other purposes. All contact information provided shall also be maintained in accordance with our Privacy Policy.